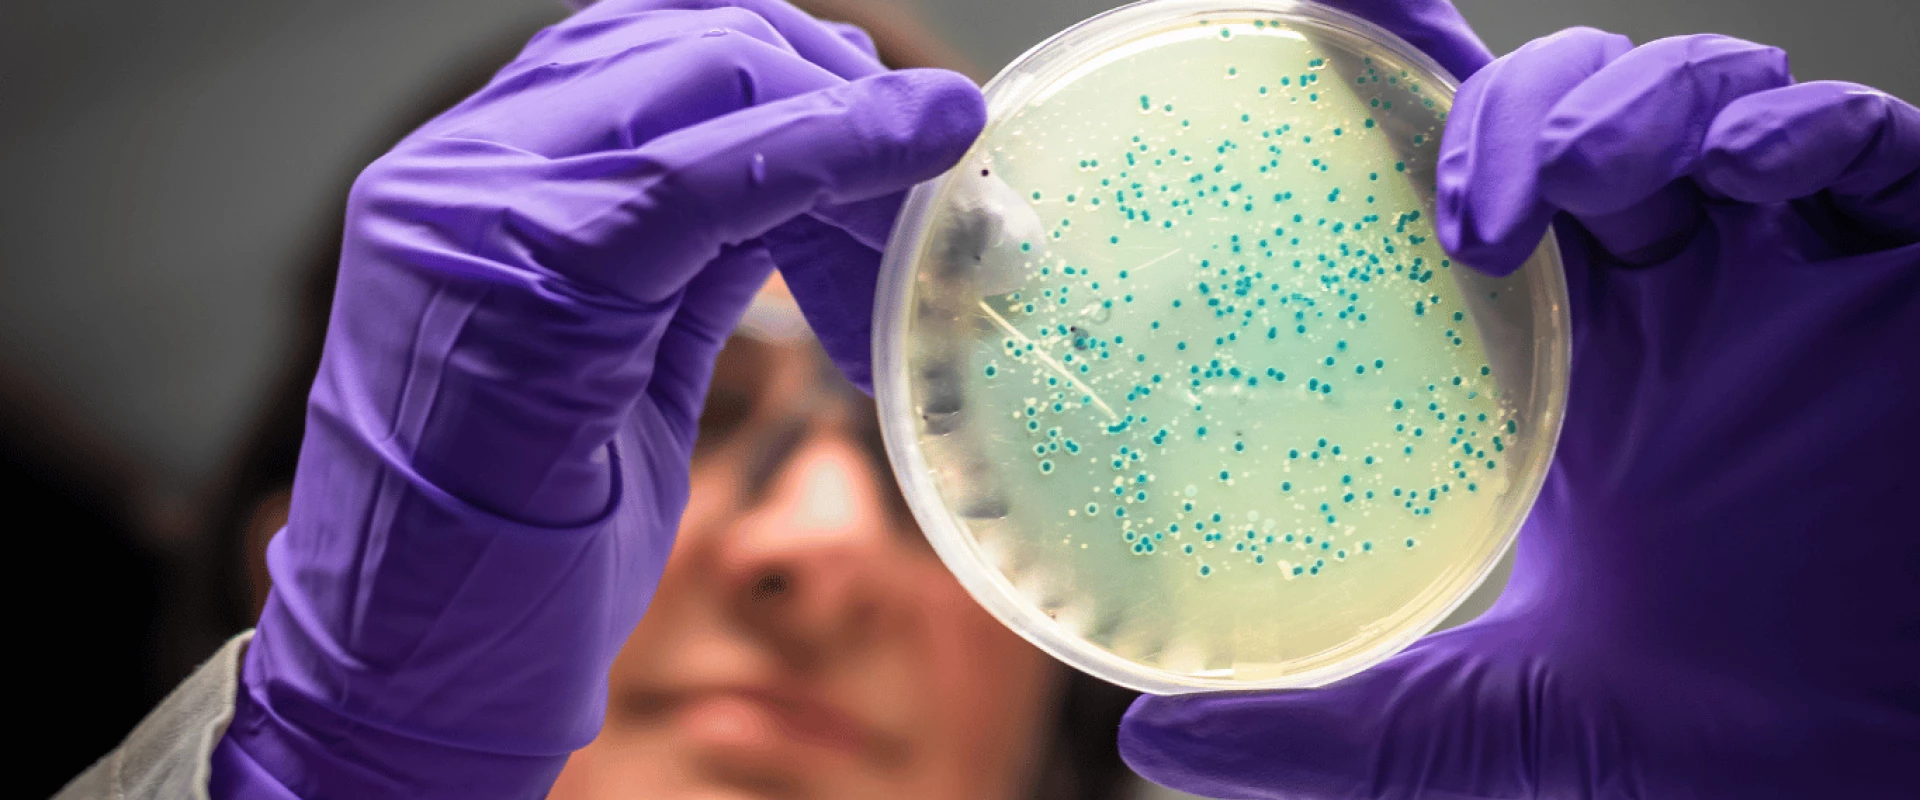
هل تحمي بكتيريا الأمعاء أجسامنا من سمّية المبيدات؟

تزداد الأبحاث التي تكشف عن الدور الخفي للميكروبيوم المعوي (مجتمع الكائنات الدقيقة التي تعيش في أمعائنا) في حماية صحتنا. ومن أحدث هذه الدراسات ما نُشر مؤخرًا في مجلة Nature Communications، والذي يسلّط الضوء على قدرة بعض البكتيريا النافعة على التخفيف من التأثيرات السامة لمبيدات الآفات.
ما هي المعززات الحيوية؟
المعززات الحيوية (البروبيوتيك) هي كائنات حية مجهرية، غالبًا بكتيريا أو خمائر، تمنح فائدة صحية عند تناولها بكميات مناسبة. وتتمثل أهميتها في الحفاظ على توازن الميكروبيوم، وهو توازن حيوي لا يساعد فقط على الهضم، بل يمنع البكتيريا الضارة من الاستقرار في الأمعاء. لكن هذا التوازن يتأثر بعوامل عديدة، منها: المضادات الحيوية، الأنماط الغذائية الفقيرة، التدخين، الكحوليات، والتعرّض للملوثات البيئية مثل المبيدات.
ماذا تقول الدراسة الجديدة؟
أجرى باحثون من جامعة ولاية أوهايو تجارب على أنواع مختلفة من بكتيريا الأمعاء، ولاحظوا أن بعض المبيدات توقف نمو أنواع معينة، بينما تستطيع أنواع أخرى حجز جزء من هذه المبيدات داخل خلاياها. وفي تجربة لاحقة على فئران، وُجد أن وجود بكتيريا محددة ساعد على تخفيف الالتهاب الناتج عن التعرض للمبيدات مقارنة بالفئران الأخرى.
ويقول الباحث المسؤول، البروفيسور جيانغجيانغ زو:
«حددنا بعض الكائنات الدقيقة القادرة على تحطيم أو تفكيك جزء من المبيدات, وقد تصبح أساسا لعلاجات مستقبلية تزيل السموم من الأمعاء».
كما أشارت الدراسة إلى أن تأثير المبيدات لا يقتصر على قتل البكتيريا، بل يشمل تغيير طريقة عملها داخل الجسم، بما في ذلك إنتاج الطاقة، التواصل بين الخلايا، وتنظيم الاستجابات المناعية. وقد تُساهم البكتيريا المفيدة في التخفيف من بعض هذه التأثيرات الضارة للمبيدات، من خلال إنتاج مركبات مضادة للالتهاب أو تحمي من التلف الخلوي. لكن الباحثين يشددون على أن هذه النتائج ما زالت أولية وتحتاج إلى تجارب أوسع قبل اعتمادها كعلاج.
ما أهمية الدراسة؟
المبيدات موجودة في طعامنا ومياهنا بنسب متفاوتة، وفهم علاقتها بالميكروبيوم قد يفتح أبوابًا جديدة للوقاية. إلى أن تُثبت هذه العلاجات، يبقى دعم تنوع بكتيريا الأمعاء عبر نظام غذائي غني بالألياف والخضار والحبوب الكاملة خيارًا آمنًا لتعزيز الصحة.